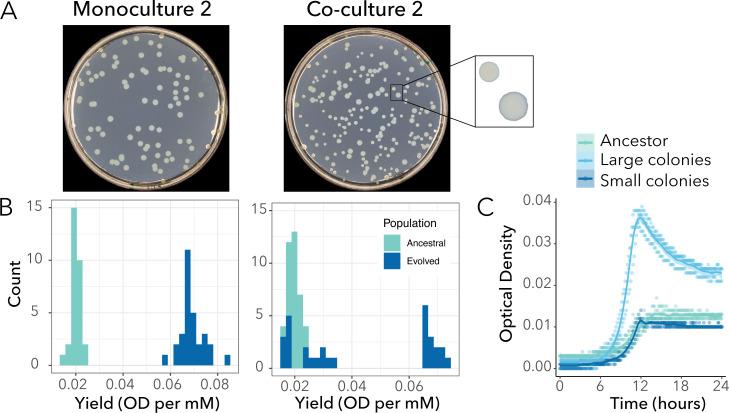
https://cdn.ncbi.nlm.nih.gov/pmc/blobs/5c75/11575400/ccedfa615b76/msystems.01053-24.f001.jpg

微生物多样化在一个经过实验进化的合成群落中得以维持。
Microbial diversification is maintained in an experimentally evolved synthetic community.
机构信息
Department of Ecology and Evolutionary Biology, University of California, Irvine, Irvine, California, USA.
出版信息
mSystems. 2024 Nov 19;9(11):e0105324. doi: 10.1128/msystems.01053-24. Epub 2024 Oct 15.
UNLABELLED
Microbial communities are incredibly diverse. Yet, the eco-evolutionary processes originating and maintaining this diversity remain understudied. Here, we investigate the patterns of diversification for evolving in isolation and with leaking resources used by . We experimentally evolved four experimental replicates in monoculture and co-culture for 200 generations. We observed that diversified into two distinct morphotypes that differed from their ancestor by single-point mutations. One of the most prominent mutations hit the gene encoding the master regulator of flagella and biofilm formation. We experimentally confirmed that mutants were unable to swim and formed less biofilm than their ancestor, but they also produced higher yields. Interestingly, the genotype and other mutations swept to fixation in monocultures but not in co-cultures. In co-cultures, the two lineages stably coexisted for approximately 150 generations. We hypothesized that modulates the coexistence of the two lineages through frequency-dependent selection. However, invasion experiments with two genotypes in monoculture and co-culture did not support this hypothesis. Finally, we conducted an evolutionary "replay" experiment to assess whether the presence or absence of influenced the coexistence of morphotypes at the population level. Interestingly, had a stabilizing effect on the co-culture. Overall, our study suggests that interspecies interactions play an important role in shaping patterns of diversification in microbial communities.
IMPORTANCE
In nature, bacteria live in microbial communities and interact with other species, for example, through the exchange of resources leaked into the external environment (i.e., cross-feeding interactions). The role that these cross-feeding interactions play in shaping patterns of diversification remains understudied. Using a simple bacterial system in which one species cross-feeds resources to a second species (commensal species), we showed that the commensal species diversified into two subpopulations that persisted only when the cross-feeder partner was present. We further observed loss-of-function mutations in flagellar genes that were fixed in monocultures but not in co-cultures. Our findings suggest that cross-feeding species influence patterns of diversification of other species. Given that nutrient leakage is pervasive in microbial communities, the findings from this study have the potential to extend beyond our specific bacterial system. Importantly, our study has contributed to answering the larger question of whether species evolved differently in isolation versus when interacting with other species.
未加标签
微生物群落的多样性令人难以置信。然而,起源和维持这种多样性的生态进化过程仍有待研究。在这里,我们研究了 在隔离和与 泄漏资源的共培养中进化的多样化模式。我们在 200 代的时间里,在纯培养和共培养中分别对四个实验重复进行了实验进化。我们观察到, 分化成两种与祖先不同的形态,其差异来自单点突变。最显著的突变之一发生在 基因上,该基因编码鞭毛和生物膜形成的主调控因子。我们通过实验证实, 突变体不能游动,并且形成的生物膜比其祖先少,但产量更高。有趣的是, 基因型和其他突变在纯培养中固定下来,但在共培养中没有。在共培养中,这两个谱系稳定共存了大约 150 代。我们假设 通过频率依赖选择调节两个谱系的共存。然而,在单培养和共培养中用两种基因型进行的入侵实验并不支持这一假设。最后,我们进行了一个进化“重演”实验,以评估 的存在或缺失是否会影响种群水平上形态的共存。有趣的是, 在共培养中具有稳定作用。总的来说,我们的研究表明,种间相互作用在塑造微生物群落的多样化模式方面起着重要作用。
意义
在自然界中,细菌生活在微生物群落中,并与其他物种相互作用,例如,通过将资源泄漏到外部环境中(即交叉喂养相互作用)进行资源交换。这些交叉喂养相互作用在塑造多样化模式中的作用仍有待研究。我们使用一个简单的细菌系统,其中一个物种将资源交叉喂养给第二个物种(共生物种),我们表明,共生物种分化成两个亚群,只有当交叉喂养伙伴存在时,这些亚群才能持续存在。我们还观察到,在单培养中固定的,但在共培养中不固定的,与鞭毛基因相关的功能丧失突变。我们的发现表明,交叉喂养物种会影响其他物种的多样化模式。鉴于营养泄漏在微生物群落中普遍存在,本研究的结果有可能超越我们特定的细菌系统。重要的是,我们的研究有助于回答一个更大的问题,即在与其他物种相互作用时,物种的进化是否与在隔离状态下不同。